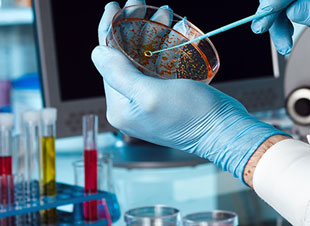

Müayinə
Müayinələr
Qida borusu xəstəliklərinin müayinəsi
Müayinə qida borusunda üzvi dəyişikliklərin olma(ma)sını araşdırmaqdan ibarətdir. Bu məqsədlə klinik və endoskopik müayinələr aparılır. Rentgenoloji müayinə...
Mədə və onikibarmaq bağırsağın xora xəstəliyinin müayinəsi
Düzgün diaqnoz qoymaq üçün rentgen müayinəsindən və qastroskopiyadan istifadə edilir. Mədənin xora xəstəliyində qabırğaaltı nahiyədə ağrılar başlayır. Çox yedikdə...
Nazik bağırsaq xəstəliyinin müayinəsi
Qarın boşluğunun bəsit rentgenoqrafiyası nadir hallarda faydalı olur. Lakin, obstruksiyası olan xəstələrdə qarın boşluğunun rentgenoqrafiyası...
Qaraciyər xəstəliklərinin müayinəsi
Qaraciyərin vəziyyətini ən doğru dəyərləndirən qaraciyər biopsiyasıdır. Fibroskanın biopsiyadan üstünlüyü ağrısız və maddi cəhətdən...
Öd kisəsi və mədəaltı vəzi xəstəliklərinin müayinəsi
Ultrasəs diagnostikası (sinonim exoqrafiya, sonoqrafiya) bugün öd kisəsi və öd yollarının müayinəsində yeganə təhlükəsiz üsullardan biridir. Müayinə adətən...
Hepatitlərin müayinəsi
Əvvəlcə, ən asan və ucuz müayinə üsulu kart-test keçirilir. Bu test çox vaxt yanlış olmur. Əgər pasiyent viruslu hepatitə yoluxubsa...
Helicobacter pylori bakteriyasınin müayinəsi
Helicobacter testi mədənin müəyyən hissələrində götürülmüş bioptatda helicobacter pylori bakteriyasını aşkarlamaq üçün istifadə olunur. Helicobacter pylori testi üçün...
Sirrozun müayinəsi
Yalnız müayinə vaxtı insanda bu xəstəliyin olmasını müəyyən etmək mümkündür. Ona görə sirrozun zamanında müəyyən edilməsi üçün...
Qastritin müayinəsi
Müalicəyə başlamadan öncə xəstəliyin yaranma səbəbinə baxılır. Əgər səbəb mədə turşuluğunun artmasıdırsa, bu halda mədə turşuluğunu...
Barret Sindromu müayinəsi
Xəstliyə diaqnoz qoymaq üçün intrumental və laborator müayinələrin nəticələri əsas götürülür. Qida borusunun rentgenoqrafiyası...
Qəbizliyin müayinəsi
Qəbizliyin həkimin konsultasiyası olmadan müstəqil müalicəsi düzgün diaqnozun qoyulmasını və müalicəni...
Köp problemi müayinəsi
Köpün müalicəsi üçün bir sıra müxtəlif üsullar tətbiq oluna bilər ki, bu həm dərmanla həmdə diet proqramları ilə ...
Acı ağız sindromu müayinəsi
Qan, nəcis analizi, USM müayinə, qastroskopiya da mütləqdir. İstənilən halda ağızda acılıq zamanı bu simptoma qarşı yox, onu yaradan səbəblərə ...
Kolit müayinəsi
Xəstəliyin klinikası, labarator göstəricilər, endoskopik müayinə və biopsiya, radioloji müayinələr və histopatolojik təhlil xəstəliyin ...
Axalaziya müayinəsi
Axalaziya diaqnostikasında tək başına yetərli və dəqiq bir üsul yoxdur. Axalaziyanın diaqnoz və differensial diaqnozu üçün ...
Kron müayinəsi
Axalaziya diaqnostikasında tək başına yetərli və dəqiq bir üsul yoxdur. Axalaziyanın diaqnoz və differensial diaqnozu üçün ...
Qastroezofageal Reflüks Xəstəliyi (QERX)
Axalaziya diaqnostikasında tək başına yetərli və dəqiq bir üsul yoxdur. Axalaziyanın diaqnoz və differensial diaqnozu üçün ...
Qlüten enteropatiyası
Axalaziya diaqnostikasında tək başına yetərli və dəqiq bir üsul yoxdur. Axalaziyanın diaqnoz və differensial diaqnozu üçün ...
Qıcıqlanmış bağırsaq sindromu
Axalaziya diaqnostikasında tək başına yetərli və dəqiq bir üsul yoxdur. Axalaziyanın diaqnoz və differensial diaqnozu üçün ...
Hepatosteatoz (qaraciyər yağlanması)
Axalaziya diaqnostikasında tək başına yetərli və dəqiq bir üsul yoxdur. Axalaziyanın diaqnoz və differensial diaqnozu üçün ...
Hepatomeqaliya (qaraciyər böyüməsi)
Axalaziya diaqnostikasında tək başına yetərli və dəqiq bir üsul yoxdur. Axalaziyanın diaqnoz və differensial diaqnozu üçün ...